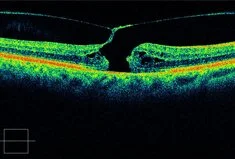

Macular Hole
Inside the Eye Macular Hole
What is a Macular Hole?
A macular hole is a hole in the centre of the retina. It happens in the most sensitive part of the retina and is important for seeing fine details as well as reading, seeing colours and recognising faces. The retina is the light-sensitive membrane at the back of the eye which sees the picture.
What are the symptoms of Macular Hole?
Patients experiencing a Macular hole may notice blurred vision, loss of central vision, and waviness of straight lines. For example, doorframes may appear crooked.
What causes Macular Hole?
The eye is filled with a jelly-like substance called vitreous. With time this may contract and pull on the Macula which causes it to tear and form a macular hole.
What is the treatment for a Macular Hole?
Various investigations and special scans can evaluate the extent and depth of the Macular Hole. Your surgeon will then advise you regarding the best course of macular hole treatment for your individual case. Macular Hole treatment may involve surgery.

Why choose SEE for Macular Hole Treatment?
We fully understand that you want the best treatment possible when it comes to Macular hole diagnosis and treatment. Rest assured, We at SEE specialise in surgical procedures and treatment for a vast number of retinal conditions with Macular Holes being one of them.
Our expert team of ophthalmic surgeons provide nothing but attention to detail but also strive to make sure you feel at ease by providing high quality patient care and personalised eye surgery.

